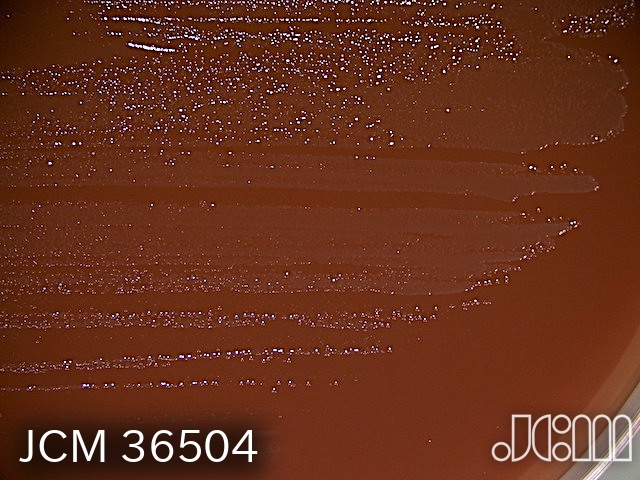

Muribaculum caecicola Afrizal et al. 2024
Taxonomy in NCBI database: Bacteria; Pseudomonadati; Bacteroidota; Bacteroidia; Bacteroidales; Muribaculaceae.
36504T <-- B. Abt; DSMZ, Germany; DSM 110169 (=NM86_A22) <-- W. Navarre; Univ. of Toronto, Canada; NM86_A22.
Accessioned in 2023.
=DSM 110169.
Type strain [13863,14365].
Medium: 14; Temperature: 37°C; Anaerobic [H2-CO2-N2 (1:1:8) gas mixture]; Rehydration fluid: 663.
open link in new window
open link in new window
Source: Cecal/colon content of an APCmin/+ Msh2-/- mouse [13863].
G+C (mol%): 45.7 (genome sequence) [13863].
Other taxonomic data: Average nucleotide identity, genome-to-genome distances, percentage of conserved proteins [13863].
Genome sequence: SSTG00000000.
NCBI Assembly ID: GCA_004801635 (GenBank), GCF_004801635 (RefSeq).
NCBI Taxonomy ID: 3038144.
Related information on delivery / use of the strainBiosafety level 1
Terms and conditions Not applicable
Export control (1) No
Distribution control in Japan (2) No
Genetically modified microorganism No
Technical information -
Additional information -
(1) in complying with the Foreign Exchange and Foreign Trade Control Law of Japan
(2) in complying with the Plant Protection Law of Japan
JCM36504